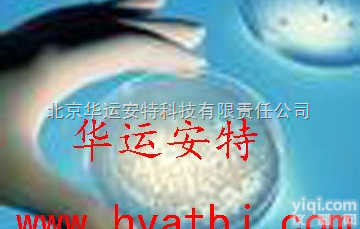
高<em>分子</em><em>复合</em>长效战备平皿  高<em>分子</em><em>复合</em>长效战备平皿

250/1600型复合质谱分子泵
- 产地:上海市
- 供应商:上海弘燊真空科技发展有限公司
- 供应商报价:面议
- 标签:250/1600型复合质谱分子泵
250/1600型复合质谱分子泵技术参数表
250/1600型复合质谱分子泵技术参数表
型号 | 250/1600 | |
抽气速率(l/s) | 1600L/S | |
压缩比N2 | <109 | |
压缩比H2 | <8×104 | |
极限压强(Pa) | <2×10-8 | <1×10-7 |
高真空法兰 | LF250 | CF250 |
排气口法兰 | KF50 | |
启动加速时(min) | <7min | |
电机转速(n/min) | 24000n/min | |
最小不平衡(mg) | 15mg | |
建议采用前级泵 | 机械泵15L/S | |
充油量(ml) | / | |
安装方式 | 垂直±5° | |
冷却方式 | 水冷或风冷 | |
冷却水温度 | <20℃ | |
环境使用温度(℃) | 风冷<32℃ 水冷<40℃ | |
泵体烘烤温度(℃) | <100℃ | |
泵重量(kg) | 40kg | |
外形尺寸(mm) | Φ340×427 | |
型号 | 250/1600 | |
抽气速率(l/s) | 1600L/S | |
压缩比N2 | <109 | |
压缩比H2 | <8×104 | |
极限压强(Pa) | <2×10-8 | <1×10-7 |
高真空法兰 | LF250 | CF250 |
排气口法兰 | KF50 | |
启动加速时(min) | <7min | |
电机转速(n/min) | 24000n/min | |
最小不平衡(mg) | 15mg | |
建议采用前级泵 | 机械泵15L/S | |
充油量(ml) | / | |
安装方式 | 垂直±5° | |
冷却方式 | 水冷或风冷 | |
冷却水温度 | <20℃ | |
环境使用温度(℃) | 风冷<32℃ 水冷<40℃ | |
泵体烘烤温度(℃) | <100℃ | |
泵重量(kg) | 40kg | |
外形尺寸(mm) | Φ340×427 | |